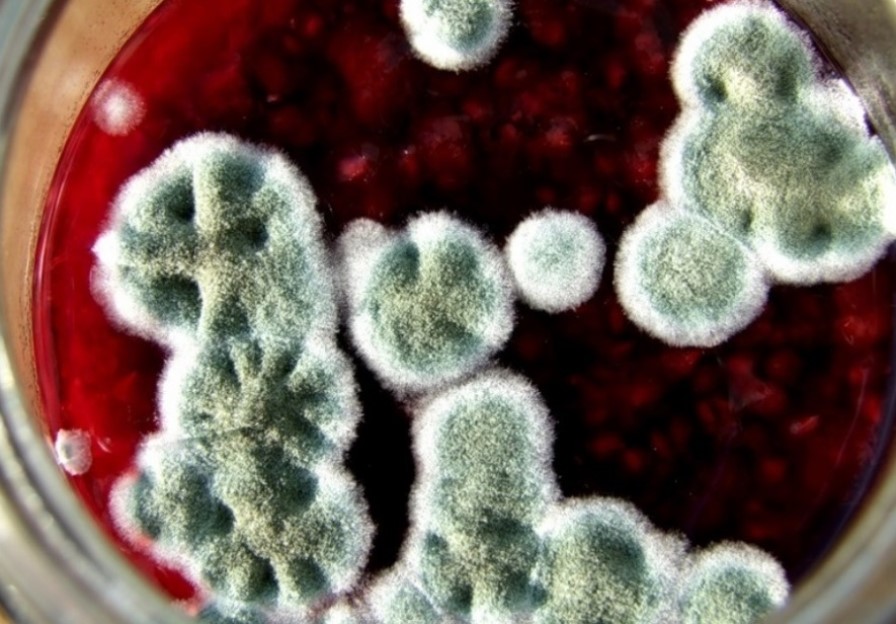
Чи можна їсти варення, на якому є пліснява?

Чи можна їсти варення, на якому є пліснява?
Фото: Чи можна їсти варення, на якому є пліснява (pixabay.com)
Якщо ви все ще доїдаєте минулорічне варення, щоб звільнити місце в погребі для нових запасів, варто знати, чи можна вживати консервацію, на якій є пліснява. Багато хто просто прибирає зіпсовану частину варення, повидла або джему і спокійно смакує вмістом банки.
Чи може таке варення нашкодити - читайте нижче в нашому матеріалі.
Чим можна просто прибрати плісняву?
Так, Британське агентство харчових стандартів не радить їсти їжу, яка явно прогнила або містить цвіль, пише BBC.
Зазначається, що це особливо важливо для людей з уразливих груп, включаючи дітей, людей похилого віку, вагітних жінок і тих, хто має ослаблену імунну систему.
Навіть якщо ви приберете плісняву, прокип'ятите варення або ж його заморозите, таке варення може бути заражене токсинами грибка, що "на око" просто не видно.
Фахівці радять утилізувати зіпсовані харчі, уражені цвіллю. Хліб, випічку варення, джем, мармелад чи інші закрутки та засолювання, покриті пліснявою, потрібно просто викинути.
Найбільш небезпечною пліснява може бути для:
- немовлят,
- дітей,
- людей літнього віку,
- людей з ослабленим імунітетом,
- людей, які мають алергії, астму, а також проблеми зі шкірою (наприклад, екзему).
На фоні серйозного зниження імунітету і високої концентрації спор плісняви, можуть виникати такі серйозні хвороби, як аспергільоз легень.
Фото: Чи можна їсти варення з пліснявою (goodhouse.com.ua)
Чому утворюється пліснява
Головна причина утворення грибка - появи конденсату при гарячому закупорюванні солодкої заготовки. Тому варення варто закочувати, коли воно прохолоне до кімнатної температури.
Інші причини появи плісняви в банках:
- Погано простерилізовані банки і кришки
- Низька герметичність закриття тари
- Недоварені ягоди
- Мало цукру в сиропі
- Різкі перепади температури в місцях зберігання
- Занадто сире приміщення при тривалому зберіганні
Тож правильно готуйте варення, а якщо відкрили банку і побачили цвіль - викидайте. Здоров'я - дорожче!
Також читайте про хитрість французьких пекарів, як зберегти хліб свіжим без холодильника.
Крім того ми писали, чим можна замінити цукор у варенні.